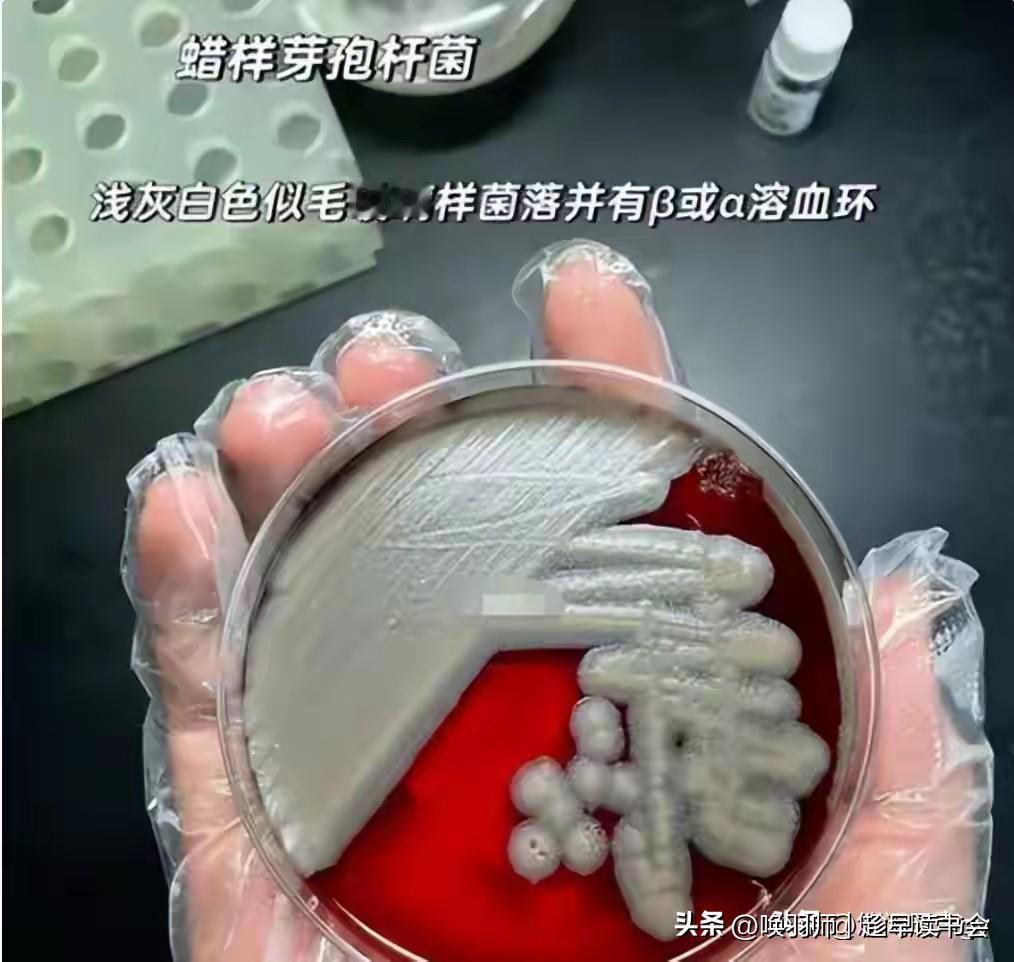

2026年1月初,雀巢因供应商提供的花生四烯酸油原料可能污染蜡样芽孢杆菌,在全球31个国家和地区召回部分批次婴儿奶粉。该细菌毒素耐热,可导致婴幼儿呕吐、腹泻及脱水。雀巢中国对跨境电商渠道相关产品启动自愿回收。 此次大品牌供应链失守,与国内近日曝光的“奶精加淀粉造假奶粉”案叠加,凸显奶粉安全新旧挑战。信息不对称是最大痛点,国内外产品名、批次不一,令家长难以及时获知风险。 家长应立即核对家中奶粉批次,并通过官方正规渠道购买。牢记监管总局“四要两不要”选购指南,认准“国食注字YP”注册号。这警示我们,保障婴幼儿口粮安全,需企业坚守供应链伦理、监管升级预防体系,家长亦需用科学知识武装自己,共同筑牢信任防线。雀巢腹泻奶粉 雀巢召回 过期奶粉 贝里奶粉 百欧克斯酪蛋白 奶粉打假 黑心奶粉 饼干防腐剂 氨基酸奶粉过敏 奶粉发霉 2025奶粉 康澳酪蛋白 雀巢麦角硫因 益生生菌奶粉 水解蛋黄奶粉